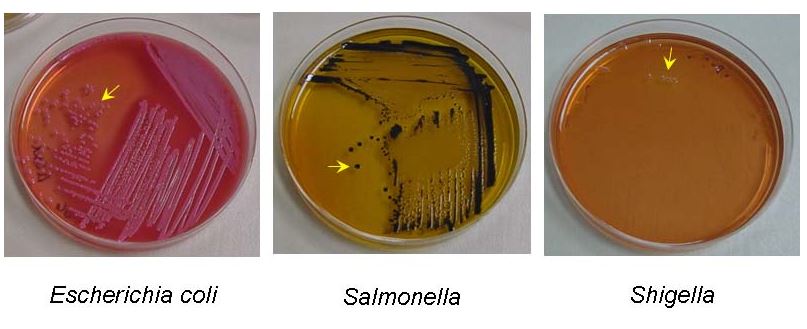
E coli Shigella Salmonella - Colony morphology ofE.coli, SalmonellaandShigellain Salmonella-Shigella Agar

Salmonella-Shigella (SS) agar is used for selective isolation and differentiation of Salmonella and Shigella. It is used for the isolation, cultivation and differentiation of gram-negative enteric microorganisms from both clinical and non-clinical specimens such as from feces, urine, and suspected food items (fresh and canned foods). This medium is not recommended for the primary isolation of Shigella as some Shigella strains may not grow on SS agar due to a relatively high level of selectivity.
Other less inhibitory media used for the isolation, cultivation and differentiation of gram-negative enteric microorganisms are:
- Desoxycholate Agar,
- MacConkey Agar,
- Eosin Methylene Blue (EMB) Agar,
- Xylose Lysine Deoxycholate (XLD Agar), and
- Hektoen Enteric Agar
Despite its name, Salmonella-Shigella (SS) agar is not suitable for isolating shigellae as it is inhibitory to most strains.
Composition of Salmonella-Shigella (SS) Agar and their function
- Lactose: fermentable carbohydrate
- Beef extract, proteose peptone: provides the nitrogen, vitamins, and amino acids in SS Agar
- Ferric citrate: Sodium Thiosulfate is also a sulfur source and acts with Ferric Citrate as an indicator to detect hydrogen sulfide production.
- Sodium thiosulphate &Sodium citrate: selective agents providing an alkaline pH to inhibit Gram-positive organisms and suppress coliforms
- Bile salts: The bile salts inhibit the growth of gram-positive microorganisms
- Brilliant Green/Neutral Red: pH indicator.
- Agar:Solidifying agent.
Final pH: 7.0 +/- 0.2 at 25ºC
Principle
The presence of bile salts mixture and dyes (brilliant green) inhibits the growth of gram-positive species to a varying degree. Differentiation of enteric organisms is achieved by incorporating lactose in the medium. Organisms that ferment lactose produce acid, which, in the presence of the neutral red indicator, results in the formation of red/pink colonies. Lactose non-fermenters form colorless colonies. The latter group contains most intestinal pathogens, including Salmonella and Shigella.
The sodium thiosulfate and ferric citrate enable the detection of hydrogen sulfide production, as evidenced by colonies with black centers.
Preparation of the media
- Suspend 60 g of the medium in one liter of deionized or distilled water.
- Mix well.
- Heat with frequent agitation and boil for one minute.
- Sterilization in an autoclave is not necessary.
- Pour into plates
- Let the agar solidify and store it in the refrigerator (avoid freezing). Prepared culture media can be kept for at least a week in refrigeration. Note: Various commercial suppliers now supplies ready-to-use culture plates.
Culturing the sample
- Allow the plates to warm to room temperature and the agar surface to dry before inoculating.
- Heavily inoculate and streak the specimen as soon as possible after collection.
- If the specimen to be cultured is on a swab, roll the swab over a small area of the agar surface.
- Streak for isolation with a sterile loop.
- Incubate plates aerobically at 35-37**°**C 18-24 hours.
- Examine colonial morphology.
Results
- **Lactose fermenter:**If lactose fermentation occurs, the medium will turn red due to the acidic pH. e.g. Escherichia coli,Klebsiella pneumoniae gives red colonies.
- Non-Lactose fermenter: Salmonella, Shigella, and other non-lactose fermenters appear as transparent or translucent colorless colonies. Colonies of Salmonella spp. may appear with or without black centers (depending on the species isolated).
| Name of the organisms | Colony characteristics in Salmonella-Shigella agar |
|---|---|
| E.coli | Slight growth, pink or red |
| Enterobacter/Klebsiella | Slight growth, pink |
| Proteus | Colorless colonies, usually with black center |
| Salmonella | Colorless colonies, usually with black center |
| Shigella | Colorless |
| Pseudomonas | Irregular, slight growth |
| Gram-positive bacteria | No growth |
Typical colonial morphology on Salmonella-Shigella Agar is as follows:
Precautions:
As SS Agar media contains components of animal origin (absence of transmissible pathogenic agents cannot be ruled out) so treat it as potentially infectious, and handle observing the usual universal blood precautions. Do not ingest, inhale, or allow the media to come into contact with skin.
References
- Image source: Collin college
- Madigan Michael T, Bender, Kelly S, Buckley, Daniel H, Sattley, W. Matthew, & Stahl, David A. (2018). Brock Biology of Microorganisms (15th Edition). Pearson.